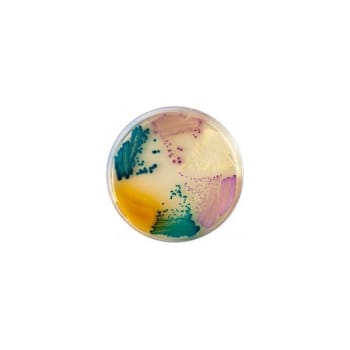
Mediq, Chrom agar plade til bestemmelse af bakterier

Mediq, Chrom agar plade til bestemmelse af bakterier
Varenr. 50038427 (Tidligere varenr. 6436016)
Salgsenhed: æske a 20 stk
Pakning: palle a 12 æske
På lager
Specifikationer
- Varenr.
50038427
- Salgsenhed
æske a 20 stk
- Pakning
palle a 12 æske
- Brand
Mediq
- Leverandørvarenr.
11611
- Dybde
18 cm
- Bredde
8 cm
- Højde
9 cm
- Bruttovægt
.363 kg
- Nettovægt
.738 kg
- Bruttovolumen
1.296 dm3
- Nettovolumen
0 dm3
- Er steril
Nej
- Indeholder latex
Nej
- Indeholder PVC
Nej
Dokumenter